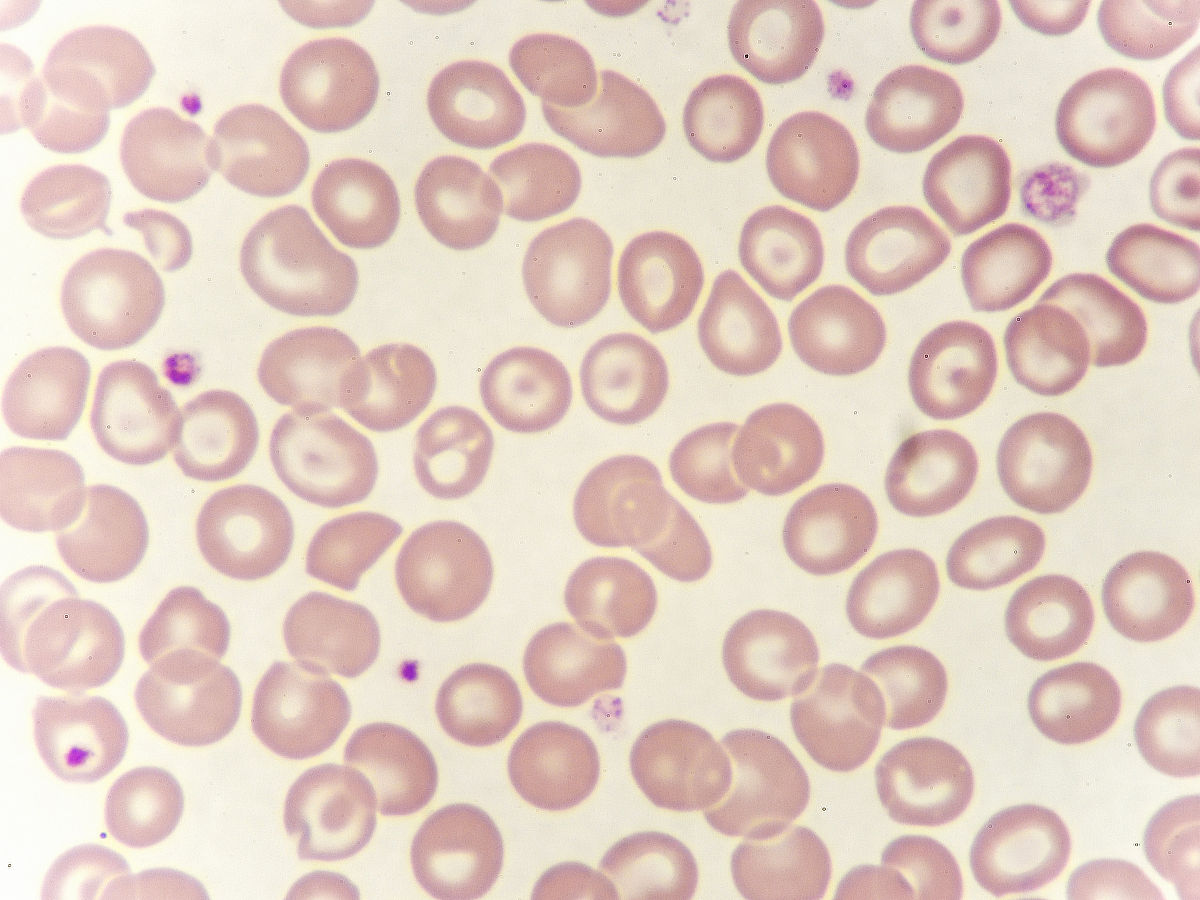
亚甲基蓝染色红细胞颜色：显微镜下观察

亚甲基蓝染色红细胞颜色:显微镜下观察
亚甲基蓝染色的红细胞是蓝色的。在显微镜下观察,经过亚甲基蓝染色后,红细胞呈现出明显的蓝色。这种颜色变化是由于亚甲基蓝与红细胞中的血红蛋白结合而产生的。亚甲基蓝染色是血液学中常用的染色方法,可以帮助识别红细胞形态和数量,诊断一些血液疾病。

原文地址: https://www.cveoy.top/t/topic/lTVp 著作权归作者所有。请勿转载和采集!
安全问答是一个知识全球问答,包含丰富的问答知识
亚甲基蓝染色的红细胞是蓝色的。在显微镜下观察,经过亚甲基蓝染色后,红细胞呈现出明显的蓝色。这种颜色变化是由于亚甲基蓝与红细胞中的血红蛋白结合而产生的。亚甲基蓝染色是血液学中常用的染色方法,可以帮助识别红细胞形态和数量,诊断一些血液疾病。
原文地址: https://www.cveoy.top/t/topic/lTVp 著作权归作者所有。请勿转载和采集!